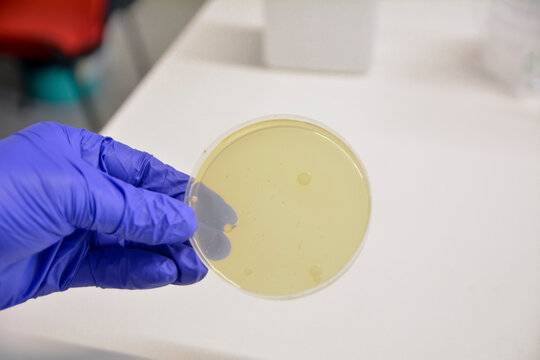

Pseudomonas aeruginosa (von lateinisch aerugo ‚Grünspan‘) ist ein gramnegatives, oxidasepositives Stäbchenbakterium der Gattung Pseudomonas. Es wurde zuerst durch den französischen Pharmazeuten Carle Gessard im Jahre 1882 beschrieben. Dieser isolierte das Bakterium von Wunden aus welchen blau-grüner Eiter austrat. Die Namensgebung bezieht sich dabei auf die blau-grüne Färbung des Eiters bei eitrigen Infektionskrankheiten.
P. aeruginosa ist ein wichtiger Krankenhauskeim, der gegen mehrere Antibiotika resistent ist. Durch die steigende Antibiotika-Resistenz befindet sich P. aeruginosa auf der „WHO priority list for antibiotic resistant bacteria“, welche Krankheitserreger listet, gegen die mit besonderem Aufwand nach neuen Behandlungsmethoden geforscht werden sollte.
Vorkommen
Das Bakterium ist ein weitverbreiteter Boden- und Wasserkeim (Nasskeim), der in feuchten Milieus vorkommt (neben feuchten Böden und Oberflächengewässern auch in Leitungswasser, Waschbecken, Duschen, Schwimmbecken, Toiletten, Spülmaschinen, Dialysegeräten, Medikamenten und Desinfektionsmitteln). In der Hygiene gilt es daher als bedeutender Krankenhauskeim (nosokomialer Keim). Aber auch als Lebensmittelverderber spielt es eine erhebliche Rolle, was Isolate aus Pflanzen, Früchten, Lebensmitteln und dem Darmtrakt von Mensch und Tier belegen. Es kann selbst in destilliertem Wasser oder einigen Desinfektionsmitteln überleben und wachsen, wenn kleinste Spuren organischer Substanzen vorhanden sind. Die Bakterien sind auch an der sogenannten Dieselpest beteiligt. In verfahrenstechnischen Apparaten kann Pseudomonas aeruginosa aufgrund von Biofilm- und Schleimbildung unter anderem zum Verstopfen von Rohrleitungen und zur Werkstoffschädigung führen.
Aussehen
Das Stäbchen kann 2–4 µm groß werden und besitzt büschelige lophotriche Flagellen. Haftfimbrien ermöglichen es dem Bakterium, sich an Oberflächen festzusetzen. Auf der äußeren Zellmembran ist ein Exopolysaccharid (Alginat) wie eine Kapsel aufgelagert. Es schützt vor Phagozyten und Antikörpern und wirkt dem Transport aus dem Respirationstrakt entgegen.
Stoffwechsel
Der Nonfermenter P. aeruginosa ist unter anaeroben Bedingungen in der Lage, Fermentation zu betreiben. Es werden Pyruvat oder Arginin fermentiert. Als wichtiger Denitrifizierer ist es ebenfalls in der Lage, unter anaeroben Bedingungen und dem Zugang zu Stickoxiden diese als terminale Elektronenakzeptoren in der anaeroben Atmung zu nutzen. Die Fähigkeit zur Denitrifikation und die Eigenschaft, Biofilme zu bilden, sind für P. aeruginosa wichtige Virulenzfaktoren (siehe Mukoviszidose). In verschiedenen Nährmedien (z. B. Cetrimid-Agar) setzt es Farbstoffe wie Pyocyanin, Pyoverdin, Pyorubin und Pyomelanin frei. Meist ist es auf Agar „metallisch-grün“ glänzend. Charakteristisch ist dabei ein als „lindenblüten-“ oder „traubenartig“ beschriebener süßlicher Geruch („Gummibärchengeruch“), der auf die Produktion von 2-Aminoacetophenon (2-AA) zurückzuführen ist. Unter anderem wegen seiner Flüchtigkeit ist 2-AA ein potentieller, für P. aeruginosa selektiver Biomarker im Zusammenhang einer Infektion bei Mukoviszidosepatienten. Außerdem scheint es Fliegen anzulocken und die Besiedlung ihres Darms zu unterstützen, ohne jedoch dabei deren Sterblichkeit zu erhöhen, wodurch es die Verbreitung von P. aeruginosa erleichtert.
Neuere Forschungsergebnisse zeigen auf, dass P. aeruginosa mit Hilfe des eigenen Verdauungsenzyms SdsA sogar Natriumlaurylsulfat (SDS) verstoffwechseln kann. Dadurch ist das Bakterium in der Lage, auch dort zu überleben, wo andere Bakterien aufgrund der hohen SDS-Konzentration abgetötet werden, beispielsweise in Shampoos.
P. aeruginosa produziert unter limitierenden Wachstumsbedingungen (z. B. Stickstoff-, Phosphat- oder Eisenlimitierung) auf Ölen (z. B. Sonnenblumenöl) aus nachwachsenden Rohstoffen sog. Rhamnolipide. Diese Biotenside werden teilweise schon im Produktionsmaßstab hergestellt und in Waschmitteln oder Kosmetika eingesetzt. Vermutlich geben die Zellen die Rhamnolipide in das sie umgebende Medium ab, um das Öl zu emulgieren und mittels Lipasen an den Wasser/Öl-Grenzflächen das Öl in Fettsäuren und Glycerid zu spalten. Die Rhamnolipidsynthese ist durch Quorum sensing reguliert, hängt also von der Zelldichte im Medium ab. Zuständig hierfür sind das Las- und Rhl-regulierte Quorum sensing.
Genom
Im Jahre 2000 wurde erstmals das vollständige Genom des Stammes PAO1 sequenziert. Das Genom hat eine Größe von 6,3 Mbp und enthält 5570 Gene. Das Genom von P. aeruginosa enthält eine Vielzahl von Transkriptionsfaktoren und Regulatoren, welche es dem Bakterium ermöglichen sich auf verschiedenste äußere Einflüsse anzupassen. Studien, welche das Genom von verschiedenen P. aeruginosa Stämmen analysierten, fanden ein Pseudomonas pan-Genom welches 54272 Gene umfasst. 665 „essenzielle Gene“ 25420 „flexible Gene“ und 27187 „einzigartige Gene“. Durch horizontalen Gentransfer ist P. aeruginosa in der Lage neues genomisches Material zu akquirieren und dadurch neue Resistenzen zu erhalten. Darüber hinaus wurden in einigen P. aeruginosa Genomen Prophagen gefunden.
Pathogenität
Das Bakterium ist ein Krankenhauskeim, der durch seinen Stoffwechsel und seine Zellmembranstruktur Mehrfachresistenzen gegenüber Antibiotika aufweist. Mit ca. 10 % aller Krankenhausinfektionen gehört P. aeruginosa zu den in Deutschland am häufigsten auftretenden Krankenhauskeimen.
Das Spektrum an Krankheiten, welche durch diese Bakterien verursacht werden, ist umfangreich. Das häufigste Erscheinungsbild sind Pneumonien bei zystischer Fibrose und Patienten mit "Chronischer obstruktiver Lungenerkrankung (COPD), die vor allem bei immunsupprimierten und AIDS-Patienten besonders schwerwiegend sind. Harnwegsinfekte, Enterokolitis, Meningitis, Otitis externa („swimmer’s ear“) oder Infektionen auf Brandwunden können ebenfalls ausgelöst werden.
Auslöser dafür sind zum einen die Fähigkeit des Bakteriums zur Hämolyse und zum anderen Pathogenitätsfaktoren wie das Exotoxin A (ADP-Ribosyltransferase) sowie die Cytotoxine Exoenzym S und Exoenzym U, die das Bakterium produziert.
Meldepflicht
Nach dem Recht Sachsens ist der direkte oder indirekte Nachweis von „Pseudomonas aeruginosa mit erworbenen Carbapenemasen oder bei gleichzeitigem Vorliegen von phänotypischer Resistenz gegen Acylureido-Penicilline, Cephalosporine der dritten und vierten Generation, Carbapeneme und Fluorchinolone“ namentlich meldepflichtig bei Infektion und Kolonisation.
Veterinärmedizin
Im Folgenden werden die häufigsten tiermedizinischen Befunde aufgelistet:
- Entzündung des äußeren Gehörgangs beim Hund
- Eiterungen und Abszesse der Haut bei vielen Tierarten
- Darmentzündungen
- Euterentzündungen bei Kühen
- Scheidenentzündungen, Gebärmutterentzündung und Aborte bei Kühen und Stuten
- Traumatische Herzbeutelentzündung beim Rind
- Allgemeininfektion beim Geflügel
- Geschwürige Hornhautentzündung und Bindehautentzündung beim Pferd
- Eitrig-nekrotisierende Lungenentzündungen
- Blutende Lungenentzündung beim Nerz
- Maulschleimhautentzündungen, Abszesse und Allgemeininfektionen bei Reptilien
Therapie
- β-Lactam-Antibiotika (z. B. Piperacillin) Aminoglykoside (Gentamicin, Tobramycin)
- Cephalosporine der Generation IIIb (höhere Wirksamkeit gegen Pseudomonas spp. als Generation IIIa) (z. B. Ceftazidim, Cefepim)
- Gyrasehemmer wie Ciprofloxacin oder Levofloxacin
- Als Reserveantibiotika werden Carbapeneme (z. B. Imipenem oder Meropenem) und zunehmend Colistin eingesetzt.
- Weitere Antibiotika: Das Monobactam Aztreonam
Wegen der Gefahr von Resistenzentwicklungen sollte keine Monotherapie, sondern (möglichst nach Antibiogramm) immer eine Kombinationstherapie durchgeführt werden. Natürliche Resistenzen bestehen gegenüber Ampicillin Sulbactam, Amoxicillin Clavulansäure, den meisten Cephalosporinen (insbesondere allen der ersten und zweiten Generation), Ertapenem, Chloramphenicol, Trimethoprim, Tetracyclinen und Tigecyclin.
Literatur
- Medizinische Mikrobiologie, Infektions- und Seuchenlehre von Rolle/Mayr, Enke Verlag, Stuttgart 2007
- Frank Dara: Research topic on Pseudomonas aeruginosa, Biology, Genetics, and Host-Pathogen Interactions. In: Frontiers in Microbiology 2(2012) (Editorial)
- Markus Wloka: Rheologische Untersuchungen an nativen Biofilmen von Pseudomonas aeruginosa, Dissertation, Dortmund 2006
Weblinks
- P. aeruginosa in handelsüblichen Zigaretten
- Leckerer Seifenschaum. (P. aeruginosa auch in Shampoo lebensfähig). Auf: wissenschaft.de vom 20. Mai 2006
- The Pseudomonas Genome Project schlüsselt das komplette Genom von P. aeruginosa auf.
- www.systomonas.tu-bs.de – Systembiologische Datenbank zu Pseudomonaden
- Marion Martin: Den Gegner platzen lassen. Auf: wissenschaft.de vom 20. Juli 2011.
- Johanna M. Sweere et al.: Bacteriophage trigger antiviral immunity and prevent clearance of bacterial infection, Science Band 363, Nr. 6434, 29. März 2019, eaat9691, doi:10.1126/science.aat9691 – über Pseudomonas aeruginosa filamentous phages (Pf-Phagen), Inoviridae. Dazu:
- UM researchers publish new discoveries on bacterial viruses, auf: EurekAlert!, 1. April 2019, Quelle: University of Montana
- Teiji Sawa, Masaru Shimizu, Kiyoshi Moriyama, Jeanine P. Wiener-Kronish: Association between Pseudomonas aeruginosa type III secretion, antibiotic resistance, and clinical outcome: a review, in: Crit Care. 18(6), 13. Dezember 2014, S. 668, doi:10.1186/s13054-014-0668-9, PMID 25672496, PMC 4331484 (freier Volltext)
- Alexander S. Moffett, Peter J. Thomas, Michael Hinczewski, Andrew W. Eckford: Cheater suppression and stochastic clearance through quorum sensing. In: PLOS, 28. Juli 2022; doi:10.1371/journal.pcbi.1010292. Dazu:
- Felicity Nelson: 'Spiteful' Bacteria Would Rather Starve Their Colony Than Let Freeloaders Thrive. Auf: sciencealert vom 7. August 2022.
- P. aeruginosa–Nachweise bei zwei Hunden in den USA (April 2024)
Einzelnachweise
![]()